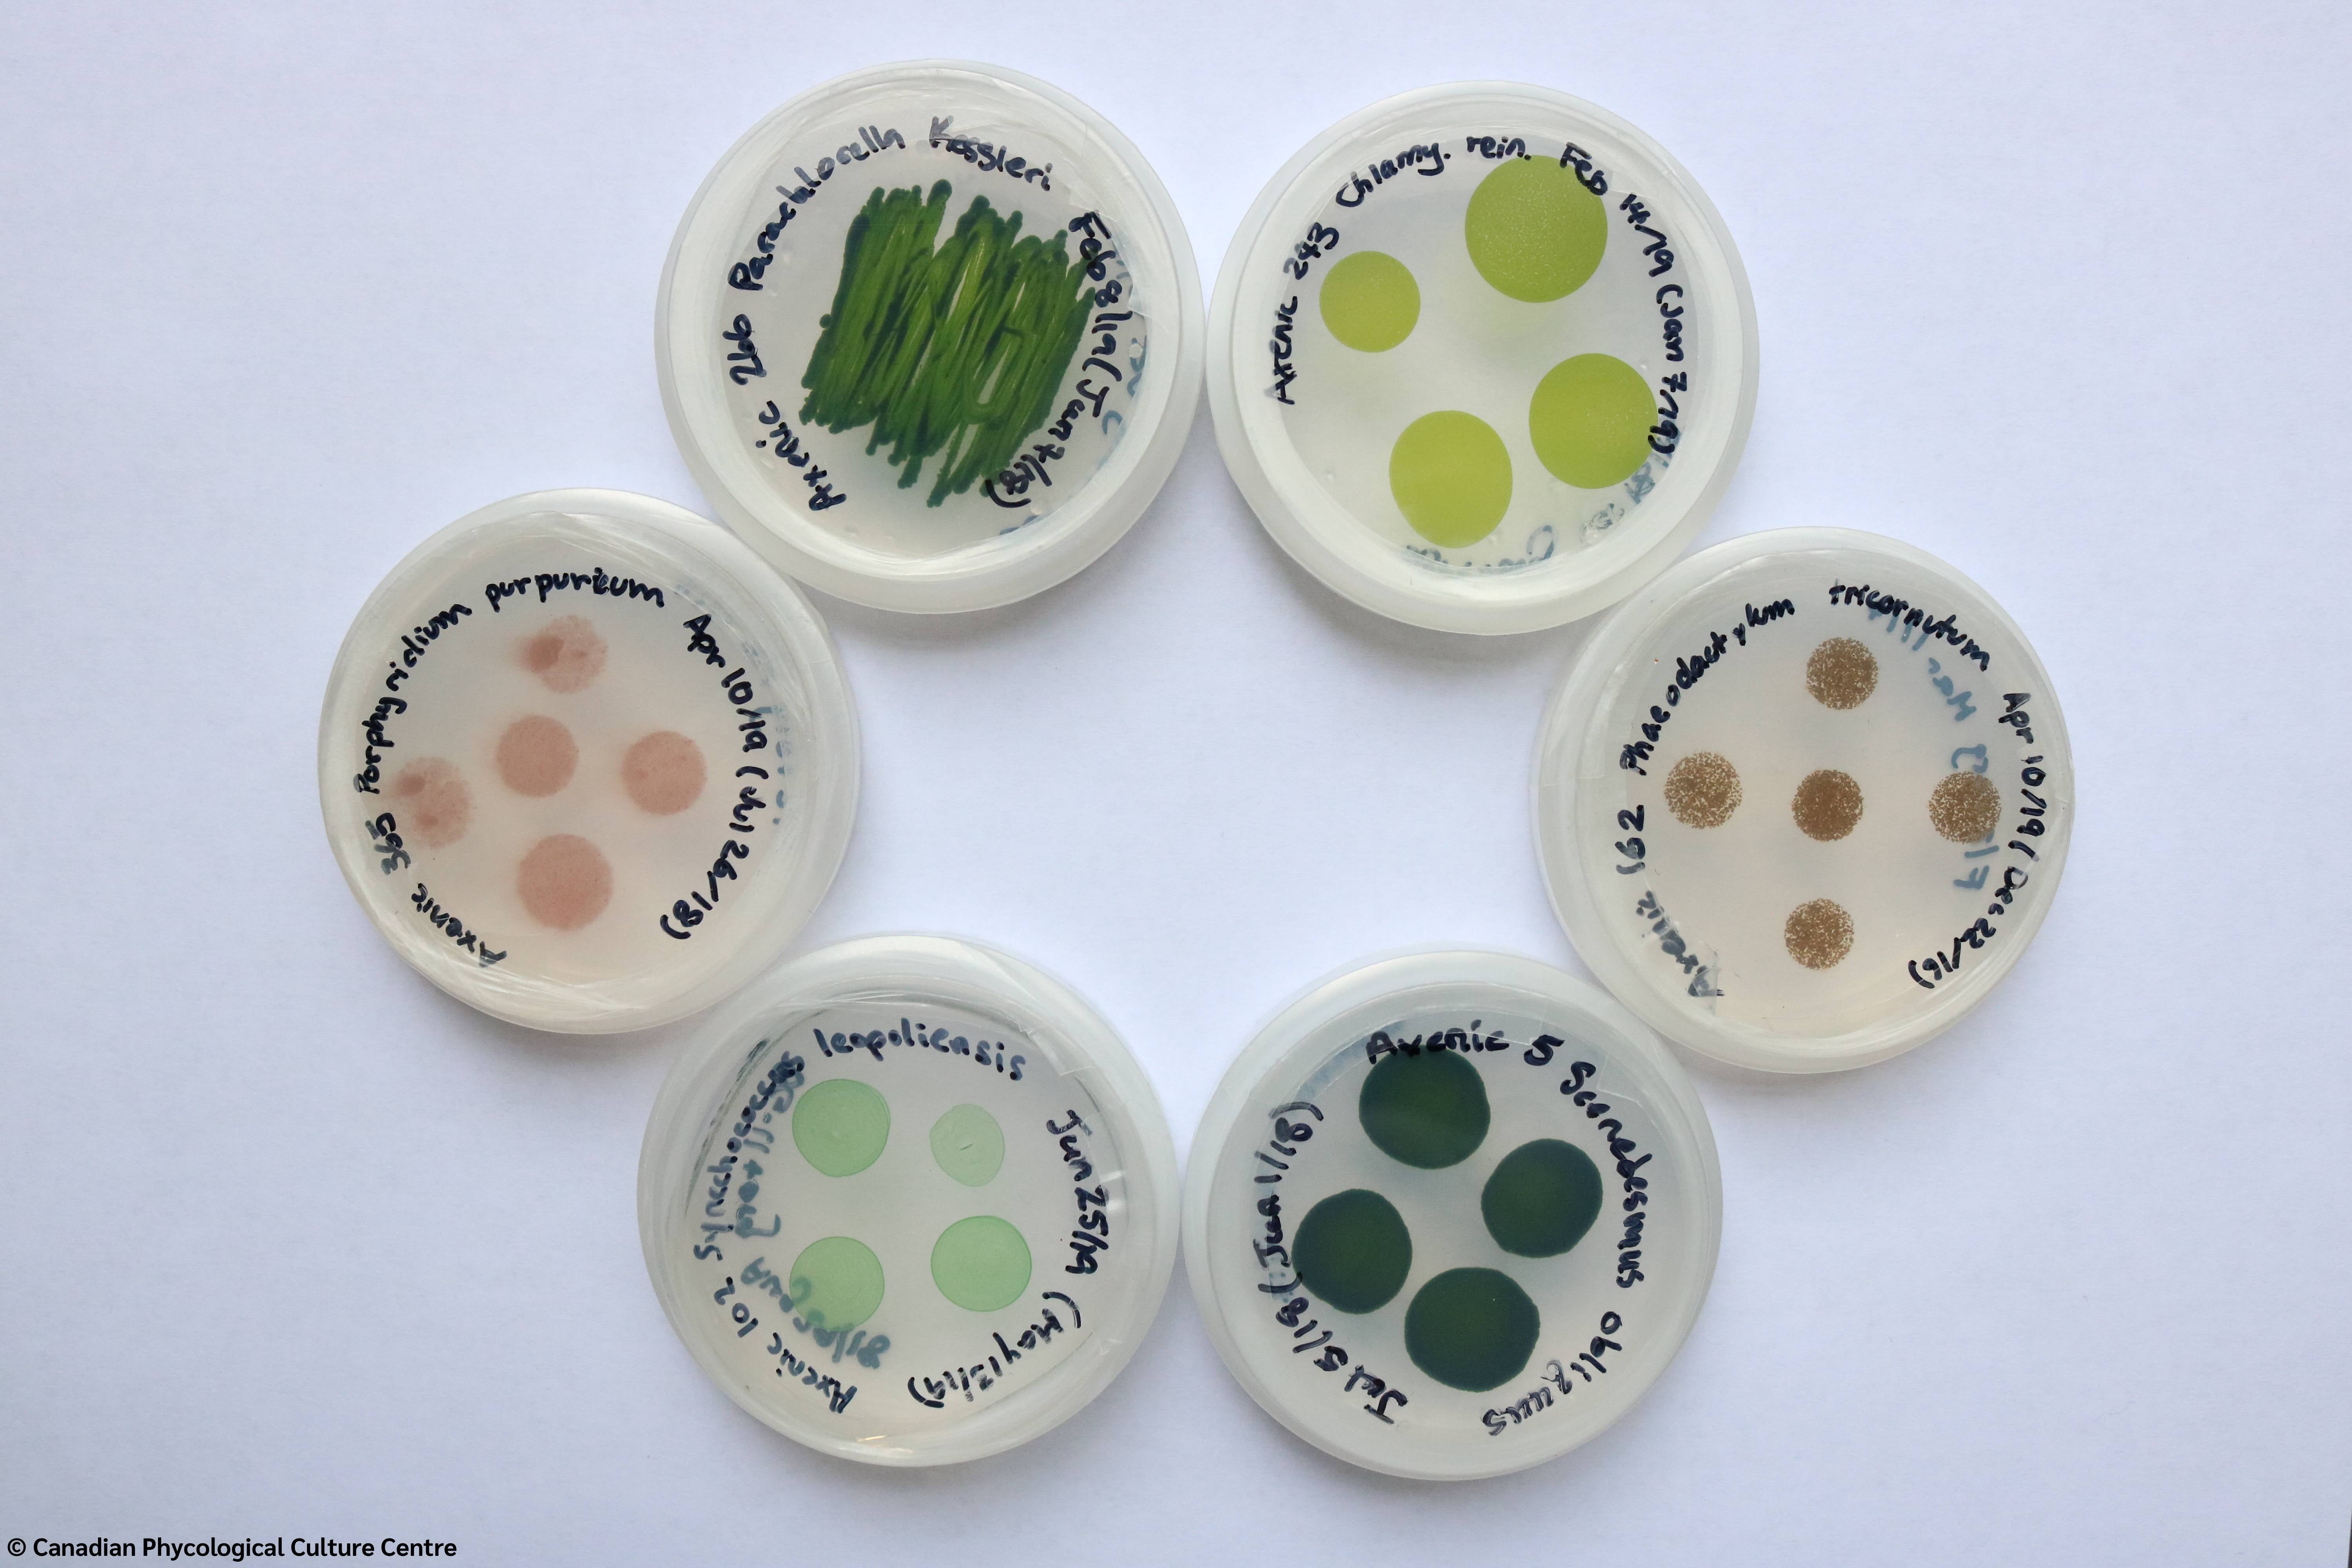

Algae may call to mind discoloured pool water or the green film floating to the top of your rain barrel, but they're much more than a summertime nuisance. Algae have applications from carbon sequestration to ecotoxicity testing to biofuel, applications made possible by the collection housed here at the University of Waterloo.
The Canadian Phycological Culture Centre (CPCC), currently housed at Waterloo, is the largest public collection of freshwater algae in Canada. This living library preserves algal strains, more than half of which are native to Canada, ensuring these genetically stable, authenticated, diverse strains remain available for research, teaching and industrial applications locally and around the world.
What started as 65 algae and cyanobacteria cultures has grown to include more than 400 strains of algae, cyanobacteria and Lemna (also known as duckweed and used for critical ecological toxicity testing). Originally opened as the University of Toronto Culture Collection in 1987, it was renamed the Canadian Phycological Culture Centre in 2008 when it moved to the University of Waterloo under the direction of Dr. Kirsten Müller in the Department of Biology.
Müller carries out research in phycology and is a world expert on the Bangiales, a group of red algae you may know as nori, used in sushi. She emphasizes that, while algae may be small, their effect is significant. "Most people think of the rainforests as the lungs of the planet, but in reality, 50 to 80 per cent of our oxygen comes from the ocean," Müller says, and that's thanks to algae.
Six plate disks with different microalgae samples. Photo credit: Canadian Phycological Culture Centre
With the collection maintained through the CPCC, Waterloo is leading the way in preserving algal biodiversity, specifically in relation to freshwater strains. Nearly 80 per cent of the strains maintained through the CPCC are unique to this collection, and approximately 60 per cent were collected from Canadian bodies of water bodies, including the Great Lakes. Through initiatives like the CPCC, Waterloo leverages its innovation mindset and collective expertise to advance global progress in environmental research and biotechnology - contributing to more sustainable futures.
Heather Roshon, technical curator of the CPCC, oversees the day-to-day operation of the collection. She maintains live cultures, provides subcultures and nutrient media, and trains researchers on maintenance, isolation and purification of strains. Roshon also provides consultation as needed and receives valuable cultures for laboratory conservation.
"Since its founding, the CPCC has supported more than 1,700 users in 36 countries, providing cultures and other services for use in academia, industry and government," Roshon says. "The CPCC is an important resource for obtaining algae, cyanobacteria and duckweed for a variety of research topics."
These cultures are used for many different applications, such as ecotoxicity testing of wastewater and developing biofuels. Cyanobacteria are critical for research into mitigating algae toxicity in nature, which is on the rise due to climate change. Algae are used in nutrition, cosmetics, dyes and living architecture, and their capacity for bioremediation and carbon sequestration helps scientists find ways to lessen the impact of pollutants in the environment. Studying algae also enhances our understanding of cell structure and the beginnings of life on earth.

Eight flasks of different cyanobacteria samples. Photo credit: Canadian Phycological Culture Centre
This research would be much more difficult and time-consuming without access to the already-isolated strains in the culture collection maintained by the CPCC. It's a unique resource that fulfills a significant need.
"Living libraries like the CPCC allow researchers to conduct critical research, duplicate previous studies and expand on results obtained by researchers before them, making innovation possible," Müller says. By preserving freshwater algal biodiversity, the CPCC supports innovation in health, sustainability and industry for future generations.
If you're interested in donating to help sustain this collection, learn how to support the CPCC on their webpage.